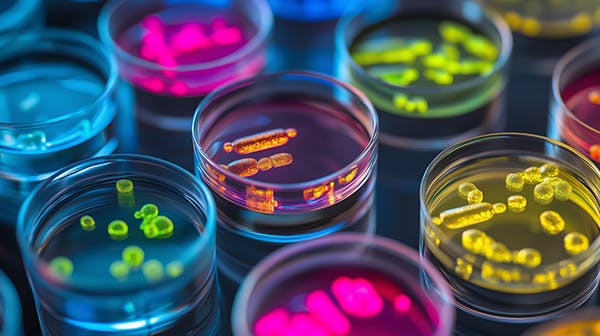
Colourful petri dishes on a dark background

Instem
Independent advice on product rationalisation
Instem sought independent technology advice to rationalise its software products, reduce technical debt, and define a cloud migration strategy. After just two weeks, our expert analysis delivered a set of evidence-based, actionable recommendations, allowing Instem to shape its strategy with confidence.
Instem is a leading provider of pharmaceutical software solutions, with a global customer base. A series of corporate acquisitions had resulted in the company owning and operating two hosted software products occupying the same market segment. Indeed, the products had previously competed for the same customers.
While the need to focus future development on just one product was obvious, the choice of product was not. The two products had very different technical histories (not all known to Instem) and significant amounts of technical debt. Furthermore, whichever product Instem decided to focus on, it would still be vital in the short term to improve the other product for its customers while lowering hosting costs and shortening maintenance cycles. This was the multi-faceted business challenge that Instem sought Scott Logic’s help to solve.

Scott Logic struck the perfect balance for us, providing independent advice without sitting on the fence. The depth of technical analysis in such a short timeframe surprised us and revealed legacy issues we hadn’t anticipated. Their clear, evidence-based insights have given us confidence in shaping our future product strategy.
Louis Brook, Chief Technology Officer, Instem
Uncovering key insights through in-depth analysis
The purpose of our comprehensive analysis of the two products was to assess and compare the viability of developing and maintaining them in relation to the costs and skills involved. From hosting and architecture down to individual lines of code, we quickly gained a deep understanding of the codebase to underpin our recommendations.
The decisive insight revealed through our analysis was that the more modern interface of one of the products concealed a stagnant backend that would be harder to maintain. This product relied on coding techniques we considered outdated, and its lack of automated testing coverage meant that any future changes would be much more costly to develop. Additionally, its single-tenant hosting model meant that any increase in the product’s customer base would result in a corresponding increase in hosting costs.
In contrast, while the other product relied largely on Citrix-hosted desktop applications, it had a high degree of automated testing coverage and a shared-tenant hosting model. Critically, Instem’s development team demonstrated expertise in the latest trends in web-hosted software application architecture and automated testing best practices. Taken together, this meant that Instem possessed a product that it could develop and scale cost-effectively, and already had all the skills in-house to achieve this commercial goal.
Recommending the right cloud migration strategy
Instem wanted to reduce and optimise the hosting costs of both products and asked us to explore the best options for moving from co-located hosting to cloud hosting. The company had already started a lift-and-shift migration of one of the products. However, like many businesses in a similar situation, Instem had found that lift-and-shift alone often does not bring any savings over co-located virtual machine hosting. Equally, they were rightly wary of tying themselves too closely to cloud-native hosting products, which can lead to vendor lock-in.
We recommended a pragmatic, cloud-agnostic migration strategy – similar to a hybrid cloud approach – that leveraged Platform-as-a-Service (PaaS) solutions while avoiding vendor lock-in. For example, we set out the benefits of migrating the products’ databases to cloud-hosted PaaS versions of well-known products to reduce maintenance overhead; at the same time, we cautioned against moving towards vendor-specific products that would tie the platform to a specific host.
Translating technical analysis into business insight
The decision about which product to invest in for the long term was ultimately a commercial one. It was therefore important for us to articulate the results of our technical analysis in business terms. As well as producing a written report for Instem, we presented our findings and recommendations to the company’s senior management and technical staff.

In these presentations, we told the development story of Instem’s products, compared them technically in accessible terms, and explained why our findings mattered relative to Instem’s future commercial goals.
In this way, our independent technology advice reassured Instem that its strategy for product rationalisation and cloud migration was achievable.
We also provided them with the evidence they needed to chart their product roadmap with confidence, safe in the knowledge that their team had the skills and knowledge required to follow that route to future commercial success.

